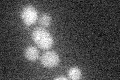
YNL148C
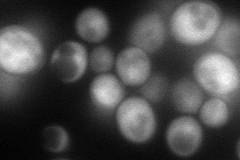
YNL148C
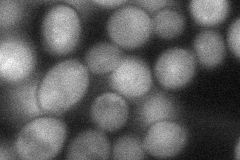
YNL148C

View description
Alpha-tubulin folding protein, similar to mammalian cofactor B; Alf1p-GFP localizes to cytoplasmic microtubules; required for the folding of alpha-tubulin and may play an additional role in microtubule maintenance
Localization:
Intensity:
Fold change:
Significance:
-
C’ GFP library in SD
below threshold15.54 -
N' NOP1pr-GFP in SD
cytosol109.34 -
N' TEF2pr-mCherry in SD

nucleus169.171 -
N' NATIVEpr-GFP in SD

cytosol26.4769 -
N' TEF2pr-VC and Cyto-VN in SD
cytosol58.5165 -
C’ GFP library in SD+DTT

cytosol18.591.19No -
C’ GFP library in SD+H2O2

cytosol16.051.03No -
C’ GFP library in Starvation Media

cytosol13.80.88No -
C’ GFP library on the background of Pup2-DaMP

below threshold -
C’ GFP library on the background of CCT mutant

below threshold17.49981.12574No
